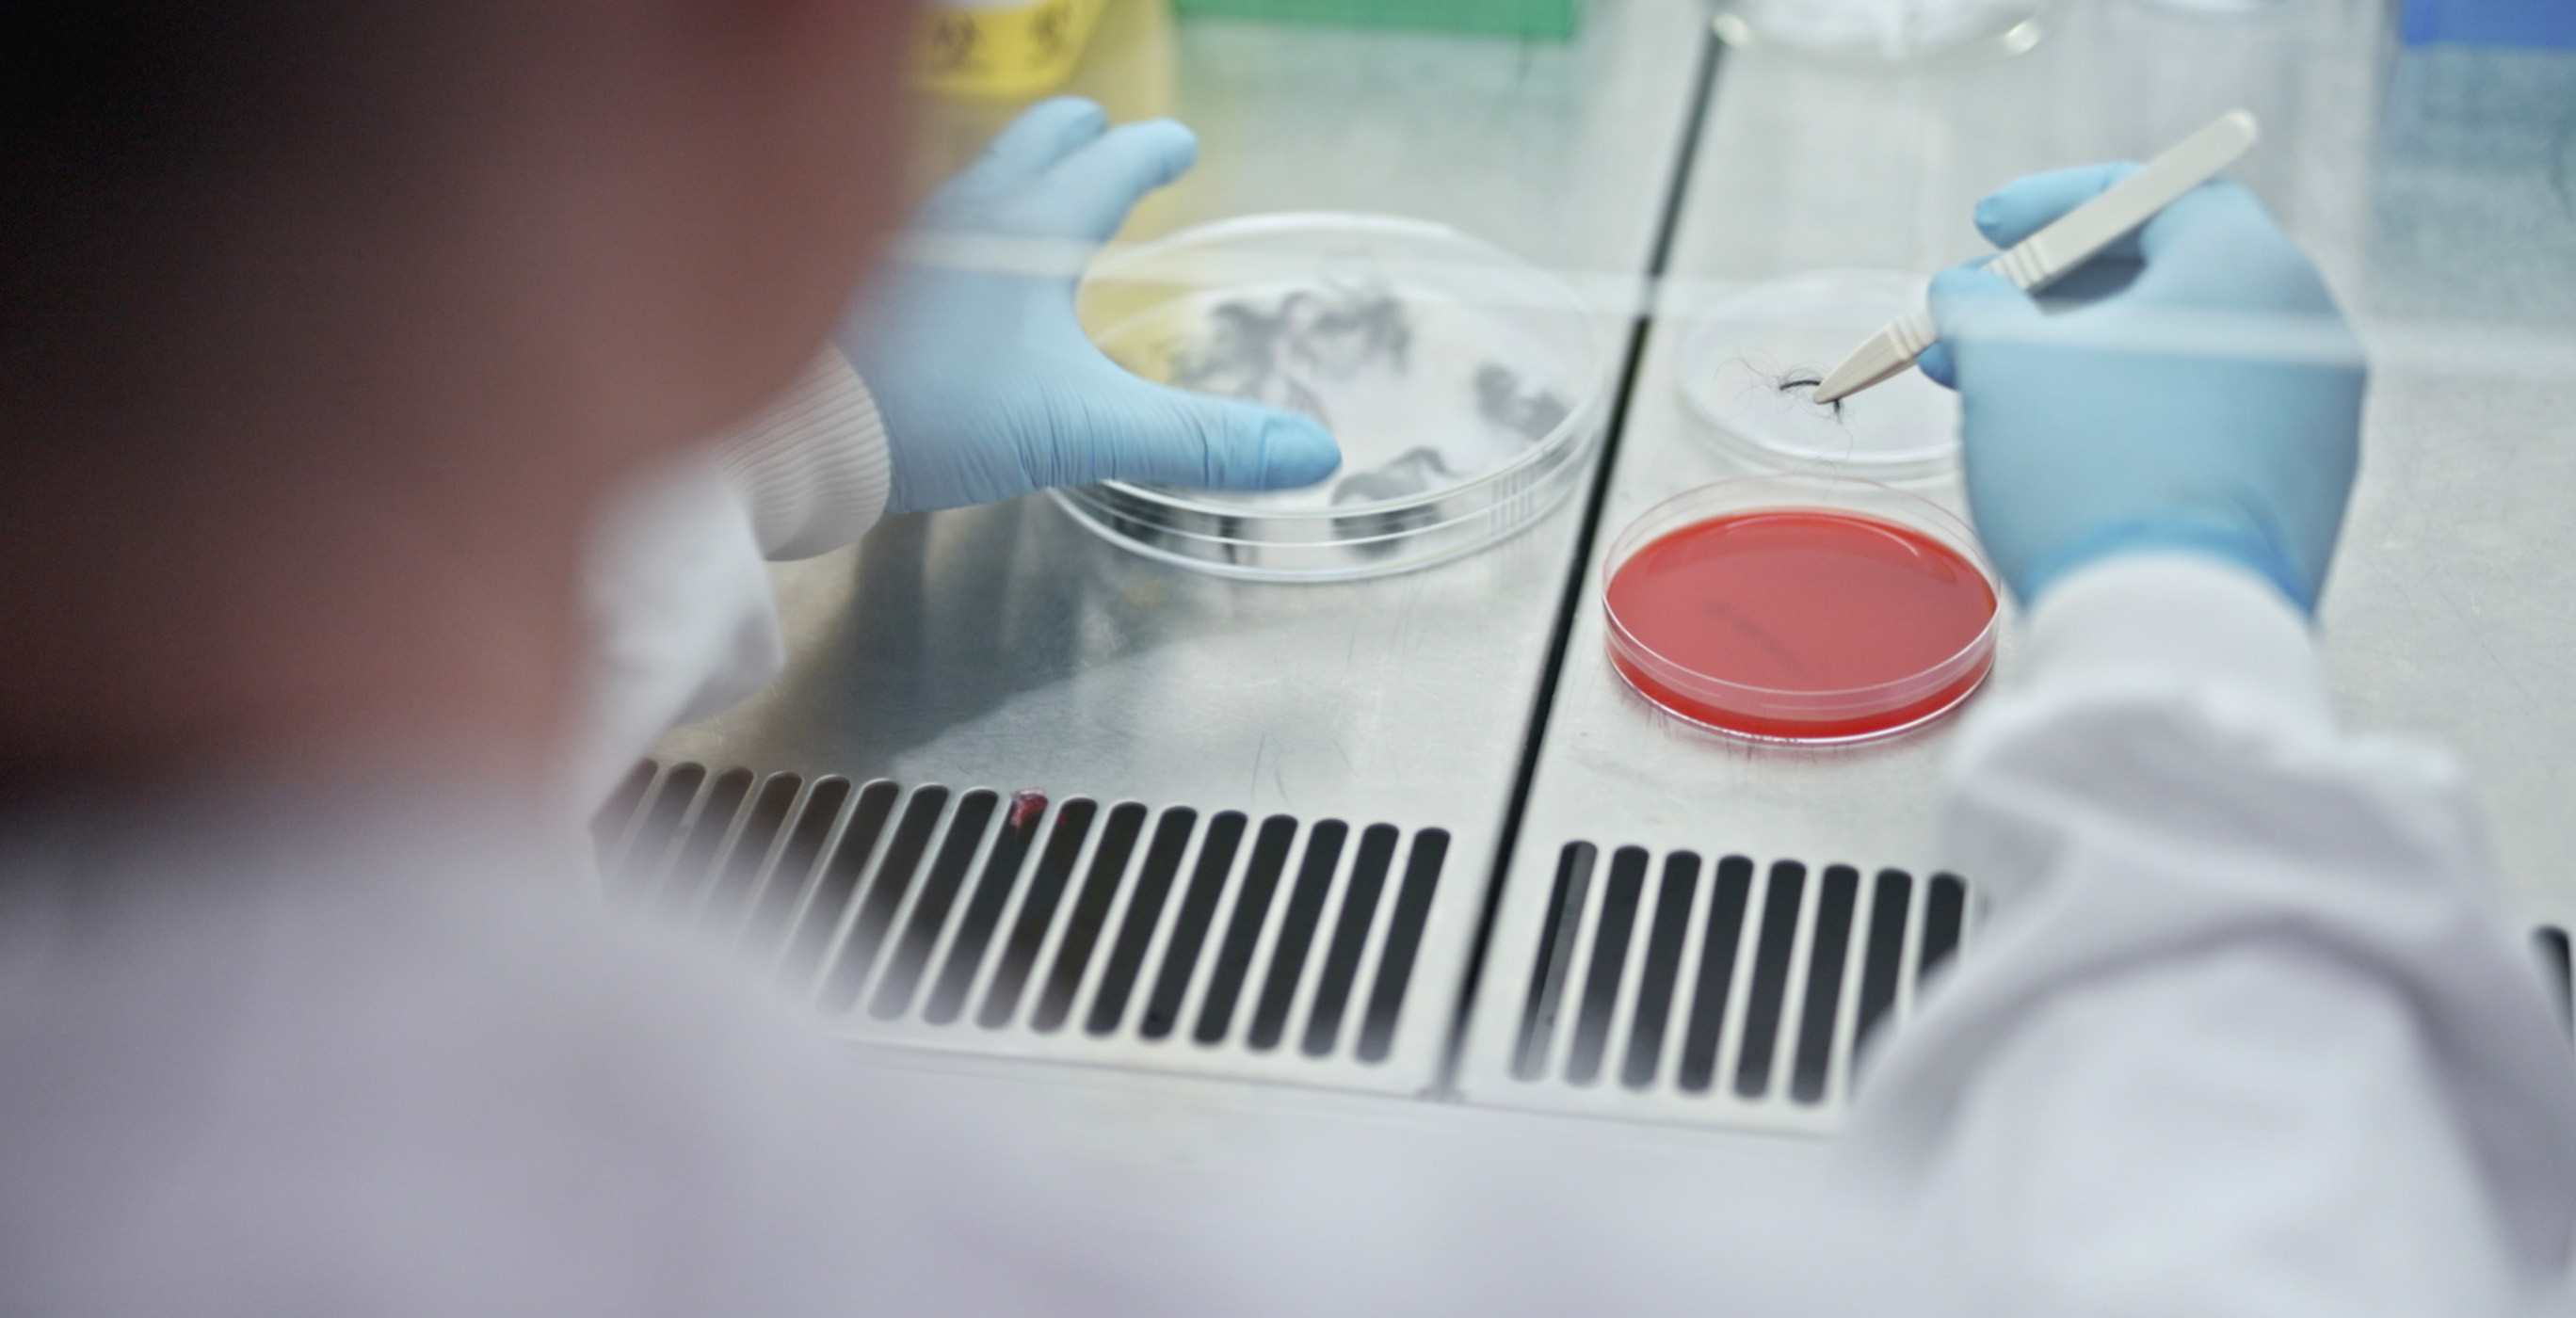
hero_01s

Τρίχες κατοικίδιων
Μπορείτε να δείτε τις τρίχες των κατοικίδιων - αλλά όχι όλη τη βρωμιά και τα άλλα σωματίδια που μπορούν να προσκολληθούν σε αυτές.1

Τρίχωμα κατοικίδιων
Το τρίχωμα των κατοικίδιων είναι ένα αλλεργιογόνο που αποτελείται από ξεραμένα κύτταρα δέρματος και σάλιο.4

Βακτήρια
Η βρωμιά από το ύπαιθρο μπορεί να προσκολληθεί στις τρίχες των κατοικίδιων - δυνητικά εξαπλώνοντας βακτήρια εάν οι τρίχες εξαπλωθούν στο σπίτι σας.4

Γύρη
Οι πατούσες και οι τρίχες των κατοικίδιων συγκεντρώνουν σωματίδια από το ύπαιθρο, που θα μπορούσαν να εξαπλωθούν σε εσωτερικούς χώρους.4



Η Dyson γνωρίζει τις τρίχες των κατοικίδιων
Οι επιστήμονές μας έχουν αφιερώσει χρόνια για να κατανοήσουν τους διαφορετικούς τύπους της τρίχας, μέχρι το πως λυγίζουν, αναπηδούν και πέφτουν.1

Και πως να τις απομακρύνει
Η τεχνολογία της κεφαλής καθαρισμού Motorbar™ της Dyson οδηγεί τις σκληρές νάιλον τρίχες βαθιά μέσα στο χαλί για να απομακρύνουν τις επίμονες τρίχες.4

Από όλες τις επιφάνειες
Η σκόνη και οι τρίχες μπορούν να προσκολληθούν στα στατικά φορτία σε σκληρά δάπεδα. Τα αντιστατικά νήματα από ίνες άνθρακα φτάνουν βαθιά για να απομακρύνουν τα μικρά σωματίδια.4

Οι τρίχες των κατοικίδιων μεταφέρουν αλλεργιογόνα
Όπου κι αν κινείται το κατοικίδιό σας, αφήνει τρίχες που μπορούν να εξαπλώσουν μικροσκοπικά αλλεργιογόνα στο σπίτι σας.

Η Dyson κοιτάζει πιο κοντά
Οι μικροβιολόγοι μελετούν τα σωματίδια που μπορούν να προσκολληθούν στις τρίχες των κατοικίδιων, βοηθώντας στην εύρεση καλύτερων τρόπων για την σύλληψή τους.

Για ένα πιο καθαρό και υγιές σπίτι
Γι' αυτό οι ασύρματες σκούπες της Dyson διαθέτουν τα εξαρτήματα , την ισχύ και το φιλτράρισμα για να συλλαμβάνουν και να περιορίζουν τα αόρατα σωματίδια.